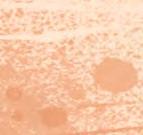

Karen Margrete Kilane
Hans Jørgen Sandnes



Norsk fra Cappelen Damm
Bokmål




Karen Margrete Kilane
Hans Jørgen Sandnes



Norsk fra Cappelen Damm
Bokmål


Huskerdudadu
Husker du da du selv lærte å lese? «Ola sa sol» og «Eli sa is». Det er magisk! Før du vet ordet av det ble kanskje Ola til Frodo og sola ble til ringen? Bøker åpner nye verdener, ideer og eventyr.
Fortellingen om Sol, Elliot, morfene og Gjemseldalen er et nytt leseunivers, som skal hjelpe nye barn inn i lesingens magiske verden. Sol og Elliot har funnet morfene i Gjemseldalen, og nå tar de vare på dem på hotellet til Elliot. Morfene kan morfe seg om til hver sin bokstav, og i boka får elevene hjelpe hver morf til å bli bokstaven.
I de elleville situasjonene morfene befinner seg i på de ulike oppslagene, får elevene utforsket bokstavenes former og lyder mens de løser morsomme oppgaver og lever seg inn i morfenes verden.
Forslag til hvordan du kan bruke boka:
•Les introteksten om hver morf sammen med eleven.
•Les bildet sammen – hva ser dere? Skjer det noe rart, fint eller gøy?
Finner dere ting på bildet med bokstavlyden det øves på?
•Se på oppgavene sammen – hvordan kan de løses?
•I oppgavene bruker vi symboler: Briller for lesing, malerkost for fargelegging og terning for spill. Blyant blir brukt til skriving, tegning, til å sette ring rundt eller trekke strek.
•Innimellom kommer oppgaver som krever litt mer forklaring.
For eksempel å løse trylleformler, spille spill, finne rim eller løse kryssord. Men de fleste oppgavene er intuitive og lette for elevene å gjøre på egen hånd.
•På repetisjonssidene som er plassert etter hver fjerde bokstav, er det mulighet for mer lese- og skrivetrening. Her kan du også sende elever som har blitt ferdig med hovedoppslaget.












































jeg er elliot. så gøy at du har kommet på besøk! bak hotellet
mitt ligger skogen og gjemseldalen. der inne bor det hekser, drager, troll og merkelige vesener. det var der inne sol og jeg fant de 29 bitte små MORFENE. i begynnelsen lå de bare i en kurv på biblioteket mens de pep og klynket. men nå har de blitt store og bråkete. kan du hjelpe oss med å passe på morfene?











= skriv = fargelegg = les = spill =















Bli med!
Vi må finne ut hvor morfene har gjemt seg!






Vi morfer kan morfe oss om til bokstaver!
































































Jeg synes stor-S og baby-s ligner på slanger!










typisk snoki å være på badet. han elsker jo skum, slim og såpebobler.
ser du hvilken bokstav han har morfet seg til?

















































































i O i l l se sel si silo s






































vi må ut for å finne isi. hun leker alltid isbil. liker du også is med insekter?






































Bare den lille i-en har prikk over seg.

bli med inn i den lille stua. men ikke tråkk på gulvet! det er lava! – du har bare lov til å hoppe på l-ord, sier lemu.

















































































Liten I er jo nesten helt lik stor I! .

















